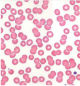
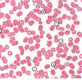
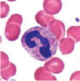
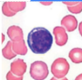

: Monocitos
: Monocitos
: Eritrocitos
: Eritrocitos
: Plaquetas
: Plaquetas
: Neutrófilios
: Neutrófilios
 : Linfocitos
: Linfocitos
 : Eosinófilo
: Eosinófilo
: Basófilo
: Basófilo
Otros juegos similares:
Otros juegos similares:





